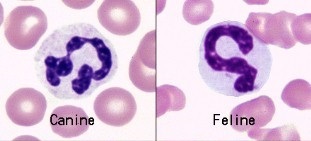
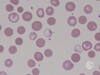

WBC
Normal Range
- 6,000-16,000 / uL
- Absolute vs %
Blood Smear WBC Count
- Normal: 10-30 WBCs per x10 counting field
- # (average) x 10 = WBCs /uL
Leukocytosis
- Elevated WBC count
- Sign of infection
- Differential to better diagnose
Leukopenia
Decrease in WBC
WBC Differentials
- Count 100 WBC
- Group each type found
- This gives the WBC percent
Absolute WBC
% on count x total WBC count
* turn % into decimal
* answer in /uL
* most important value
WBC Count Corrected for nRBC
(WBC Count x 100) / (100 + nRBC Count)
* do when more than 5 nRBC
* use this new WBC count for absolute value
Granulocytes
Which Cells
- Neutrophils
- Eosinophils
- Basophils
Agranulocytes
Which Cells
- Lymphocytes
- Monocytes
WBC Maturation
- Myeloblasts
- Promyelocyte
- Myelocyte
- Metamyelocyte
Metamyelocyte
- Stage where WBC diferentials branch off (N, B, E)
- Can be found in circulation in severe infection / inflammation
- Kidney-bean shapped
Neutrophils
- Most circulating WBC
- First line of defense
- Phagocytosis
Neutrophil Normal Range
3,000 - 11,300 /uL
Segmented vs Banded Neutrophils
- Segmented = most mature
- Band = immature
Banded Normal Range
0 - 400 /uL
* left shift when >500 /uL
Segmented Neutrophils
Most abundant WBC in domestic species (except ruminants)
* when in doubt, assume segmented
Banded Neutrophils
- Same width throughout entire nucleus
- Only see with leukocytosis
Neutrophilia
- High neutrophil count
- Acute inflammation
Neutropenia
- Low neutrophil count
- Severe infection
Neutrophilia w/ Left Shift
- Bone marrow releases bands to meet demands
- Segs > Bands
Neutropenia w/ Degenerative Left Shift
- Bands > Segmented
- Poor Prognosis
- May see Metamyelocytes
Neutrophils
SMILED
When stressed, you should smile
* Segs and
* Monos
* Increased
* Lymphs and
* Eosins
* Decreased
Lymphocytes
- Immune function
- Second most common WBC